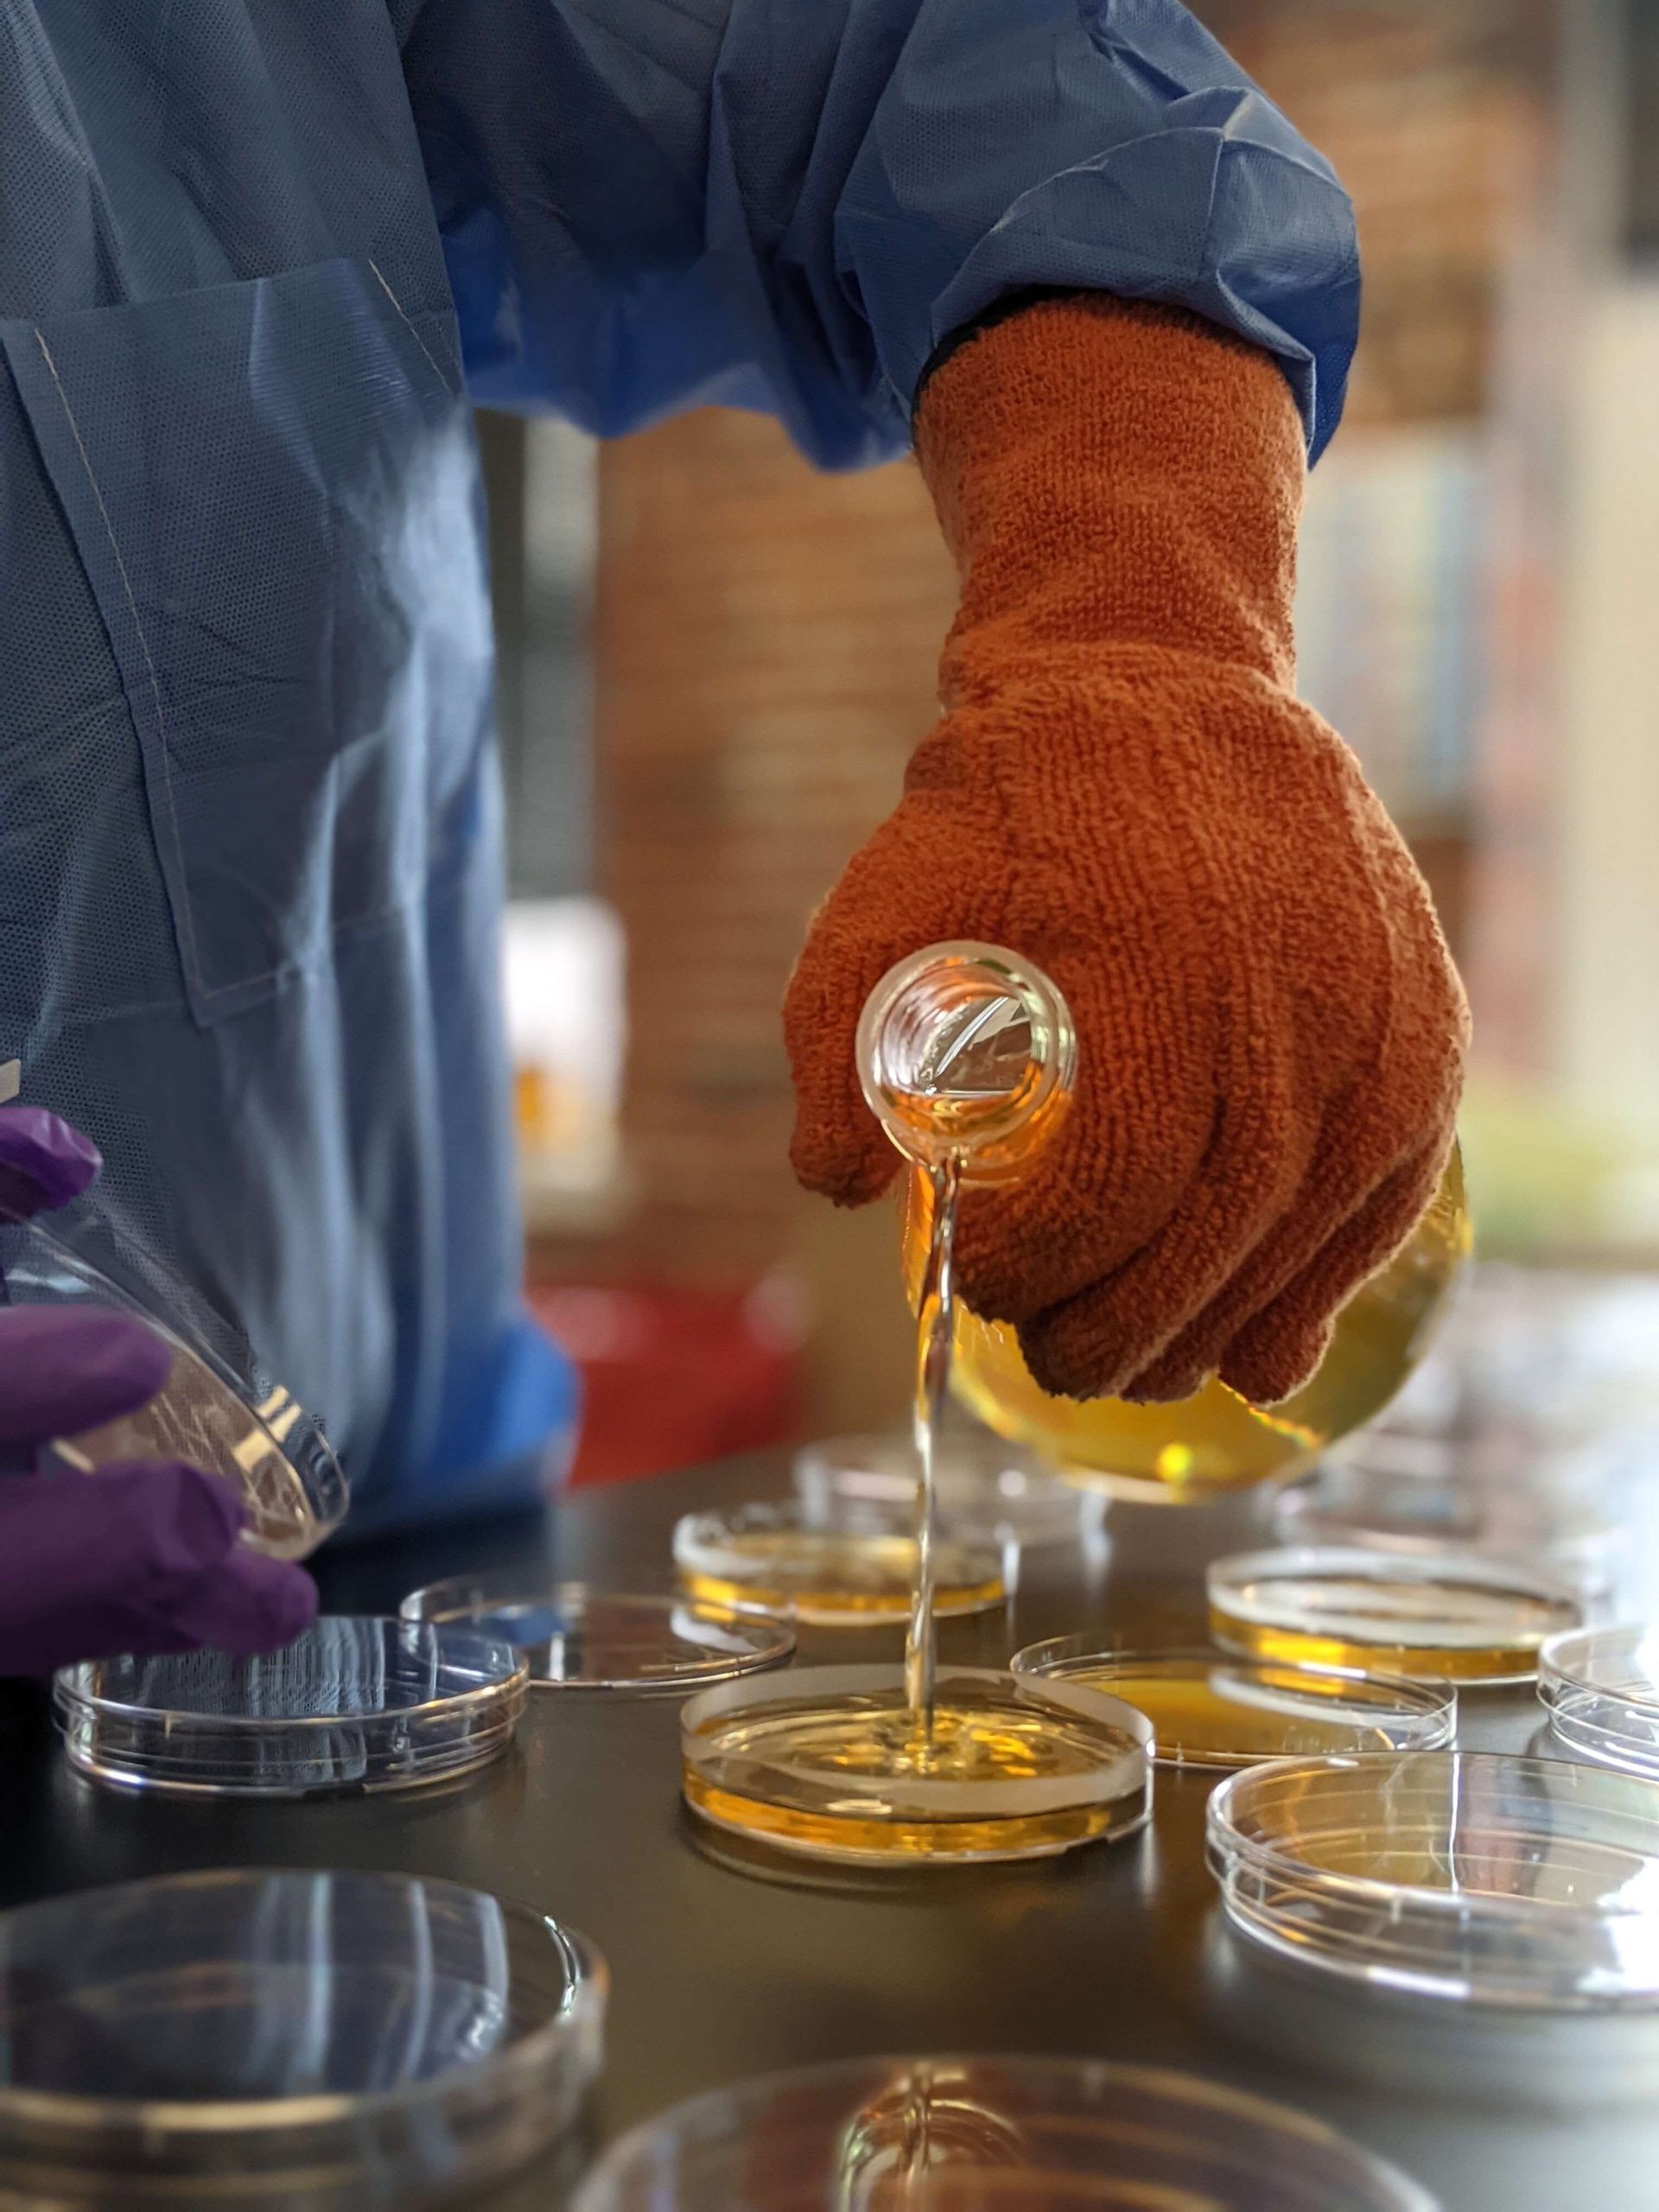

Alternatives to F-Gas Refrigerants
In the journey towards a more sustainable future, our Assessment of Alternatives to F-Gas Refrigerants explores the significant challenges facing the refrigeration and air conditioning sectors: the widespread use of fluorinated gases (F-gases). Currently, over 80% of global HVACR systems rely on these gases, particularly hydrofluorocarbons (HFCs), which are known for their alarming global warming potential—thousands of times greater than that of carbon dioxide (CO₂). Recognizing the urgent need to combat climate change, the Kigali Amendment to the Montreal Protocol has set ambitious goals to phase down HFCs due to their detrimental effects on the environment.
 However, the transition to alternative refrigerants is not without its complications; many substitutes may pose their own risks, raising concerns about pollution from substances like per- and poly-fluoroalkyl substances (PFAS) and the use of hazardous chemicals in their production. This scenario risks the potential of simply shifting from one environmental crisis to another.
However, the transition to alternative refrigerants is not without its complications; many substitutes may pose their own risks, raising concerns about pollution from substances like per- and poly-fluoroalkyl substances (PFAS) and the use of hazardous chemicals in their production. This scenario risks the potential of simply shifting from one environmental crisis to another.
Despite these challenges, there are safer and more effective alternatives available. Refrigerants such as carbon dioxide (CO₂), ammonia (NH₃), and hydrocarbons (like propane) offer promising solutions but necessitate further technological advancements for broader adoption across the industry.
In this report, we highlight the growing trend among equipment manufacturers who are transitioning to non-F-gas refrigeration systems, driven by the increasing demand for safer refrigerant options. This analysis aims to equip stakeholders—ranging from businesses to policymakers—with comprehensive information regarding the safety, effectiveness, and affordability of non-HFC refrigerants, thereby guiding sustainable decisions in HVACR practices.
Our methodology carefully examines the environmental impact, human health hazards, economic feasibility, and social implications associated with various refrigerants throughout their life cycles. We believe that informed choices are crucial for fostering a healthier planet.
Given recent technological progress and proven instances of successful adoption, it is feasible to completely transition from F-gas refrigeration systems to alternative, non-halogenated, non-PFAS refrigerants.
As we strive for progress, it is clear that without accelerated policy interventions to champion safe alternatives, the phasedown of HFCs may inadvertently lead to additional public health and environmental challenges.
This report encapsulates the critical points surrounding the complex landscape of HFCs and their alternatives, underscoring the potential for meaningful change within the HVACR industry. We invite you to explore these insights and join us in the pursuit of a more sustainable and equitable future.
Read the reportKey Takeaways
The following are some of the key findings from assessing alternatives to F-gas refrigerants:
- While HFCs pose grave threat, existing laws and policies aimed at reducing the use of HFCs pose a serious risk of substituting one environmental crisis with another.
- Of particular concern is the potential for increased pollution from per- and poly-fluoroalkyl substances (PFAS), which are already a significant public health crisis for many communities. Furthermore, hydrofluoroolefins (HFOs), a leading alternative to HFCs, may not mitigate climate change as much as anticipated or required.
- Safer alternatives to F-gas refrigerants exist. The adoption of non-fluorinated HVACR for various applications illustrates their availability and accessibility.
- Evaluation of the performance of non-F-gas refrigeration technologies increasingly illustrate the economic and social benefits of such technologies.

Contents
Executive Summary
More than 80% of global Heating, Ventilation, Air Conditioning, and Refrigeration (HVACR) systems utilize fluorinated gases (F-gases), particularly hydrofluorocarbon (HFC) refrigerants. Originally adopted as substitutes for ozone-depleting substances, HFCs have an astonishing global warming potential (GWP) that is thousands of times greater than that of carbon dioxide (CO2).
Thanks largely to the 2016 Kigali Amendment to the Montreal Protocol, governments have aimed to phase down HFC due to their significant yet preventable greenhouse effects. While an urgent phase-down of HFCs is essential for achieving climate change mitigation goals, problematic alternatives are being adopted despite the availability and ongoing development of safer options.
Concerns Associated with Fluorinated Refrigerants
Currently, laws and policies aimed at reducing the use of HFCs pose a serious risk of substituting one environmental crisis with another. For example, measures that will promote the uptake of alternatives to HFC do not adequately restrict the entry to toxic and otherwise hazardous refrigerants.
A particular concern is the potential for increased pollution from per- and poly-fluoroalkyl substances (PFAS), which are already a significant public health crisis in many communities. Additionally, the production of F-gas refrigerants involves using certain carcinogens, mutagens, and reprotoxic (CMR) substances alongside HFCs. Considering the lifecycle of hydrofluoroolefins (HFOs), a leading alternative to HFCs, and the ongoing presence of HFCs in HFO blends, this category of alternatives may not mitigate climate change as much as anticipated or required.
Safer Alternatives to Fluorinated Refrigerants are Available
Safer alternatives to F-gas refrigerants exist. Carbon dioxide (CO2), ammonia (NH3), and hydrocarbons (HCs), particularly propane and isobutane, are well-known refrigerant alternatives that can be safely and efficiently implemented with the right technology. These alternative refrigerants are currently available for some end-uses, such as residential, commercial and industrial refrigeration systems, while they are still being developed for residential air conditioners, heat pumps, and mobile refrigeration applications. The adoption of non-fluorinated HVACR for various applications illustrates their availability and accessibility.
Rigorous and holistic evaluations of the environmental performance of non-F-gas refrigeration technologies increasingly illustrate the economic and social benefits of such technologies. Non-fluorinated refrigerants are expected to have a lower Life Cycle Impact (LCI), with specific sustainability benefits emerging across multiple impact categories including reduced climate impact of CO2 systems through energy-efficient designs, decreased eutrophication potential from low-charge ammonia systems, lower carbon footprint from novel ammonia production methods, and minimized fossil fuel dependency through bio-based hydrocarbon production.
The information found in this report is intended to inform governments and businesses on decisions that could avoid the adoption of regrettable substitutes to F-gases. It can also inform residential customers seeking more sustainable HVACR solutions.
Read moreGoals and Objectives
Scope of this study
This report examines alternatives to legacy hydrofluorocarbon gases (HFCs) and emerging low-GWP alternatives (HFCs, hydrofluoroolefins or HFOs, carbon dioxide, ammonia, hydrocarbons, and water) across fluorinated and non-halogenated options used in vapor compression air conditioning, refrigeration, and heat pumps. We examine these refrigerants through a comprehensive lens encompassing environmental, human health, performance and economic dimensions. The analysis extends to environmental justice and socioeconomic implications throughout the life cycle, including performance metrics, implementation costs, and potential economic benefits.
While HFCs have applications beyond refrigerants, including aerosol propellants, foam-blowing agents for insulation, heat transfer liquids in industrial processes, and as precursors in the synthesis of certain PFAS, this report focuses on alternatives for HFC refrigerant gases. Our aim is to provide stakeholders with information on feasible alternatives to help in making decisions regarding the adoption of effective and affordable refrigerants that are safer over their life cycles for human health and the environment.
Read moreEnvironmental, Human Health and Safety Hazards
The analysis examines the following environmental, human health and safety (EHS) considerations
- Atmospheric hazards
- Persistence, bioaccumulation and eutrophication
- Human health endpoints
- Socio-economic considerations, including environmental justice
EHS evaluations include standard and complementary EHS evaluations, GreenScreen and Pharos, and TURI’s Pollution Prevention Options Analysis System (P2OASys).
Special attention is paid to the climate impacts of HFO degradation products and the long-term effects of trifluoroacetic acid (TFA) in the environment.
Read the analysisPerformance Assessment
This section describes the technical and economic aspects of adopting alternative refrigerants, distinguishing direct (drop-in) substitutes from those that require equipment replacement for their implementation.
It examines the action and performance of refrigerants based on various properties and considerations throughout the vapor compression cycle, including: Critical temperature and pressure, saturation pressure and temperature, specific volume and heat, thermal conductivity, viscosity, cooling capacity (CC), and stability.
The assessment of performance covers:
- Technical feasibility of drop-in substitutes;
- Limitations of retrofitting;
- US EPA SNAP approved alternatives to HFC alternatives; and
- Performance improvement opportunities for refrigeration and air conditioning in residential, commercial and mobile settings.
Economic Assessment
This section examines and compares the economics of certain alternatives, including the cost of equipment and refrigerants. In addition to techno-economic benefits, the report considers socio-economic considerations, including social costs of greenhouse gasses and PFAS pollution. The report also discusses the relationship between the economic feasibility of environmentally sound refrigerants and increasing rates of customer adoption.
Read the analysisOverall Alternatives Assessment of Refrigerant Gasses
Refrigerant alternatives to HFCs include HFOs, ammonia, hydrocarbons, and carbon dioxide. This examines the different refrigerant families’ benefits, drawbacks, and relevant lifecycle aspects, including potential mitigation measures. Based on this analysis, avoiding the use of F-gases – including both HFCs and HFOs – in HVACR is feasible.
Read the analysis